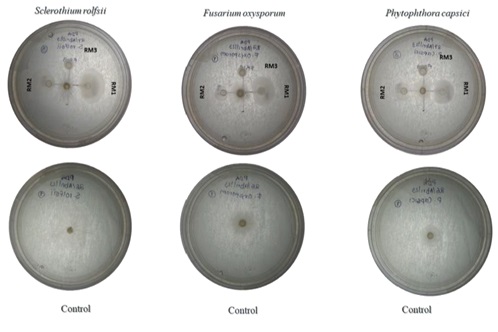

JCR
Authors
indices


![]()

![]()



![]()


Agris

incluida
Keywords
TERRA LATINOAMERICANA, Volume 44, January - December 2026, is a continuous publication edited and published by the Mexican Society of Soil Science (SMCS). P.O. Box 45, 56230 Chapingo, Mexico. Location at Soil Sciences Building, at Chapingo Autonomous University, 56230 Chapingo, Mexico. Phone: (595) 95 2 17 21. https://www.terralatinoamericana.org.mx. Editor-in-Chief: Dr. Bernardo Murillo Amador. EISSN 2395-8030. ISSN:0187-5779. Reservation of Rights to Exclusive Use of the Title: 04-2012-092017263600-203. Both given by the National Institute of Copyright (INDAUTOR).
Last Updated By: Dr. Bernardo Murillo Amador. P.O. Box 45, 56230 Chapingo, Mexico. Last Updated: January, 2026. Published articles are the sole responsibility of their authors. The reproduction of the journal is permitted, totally or partially, as long as the source is cited.